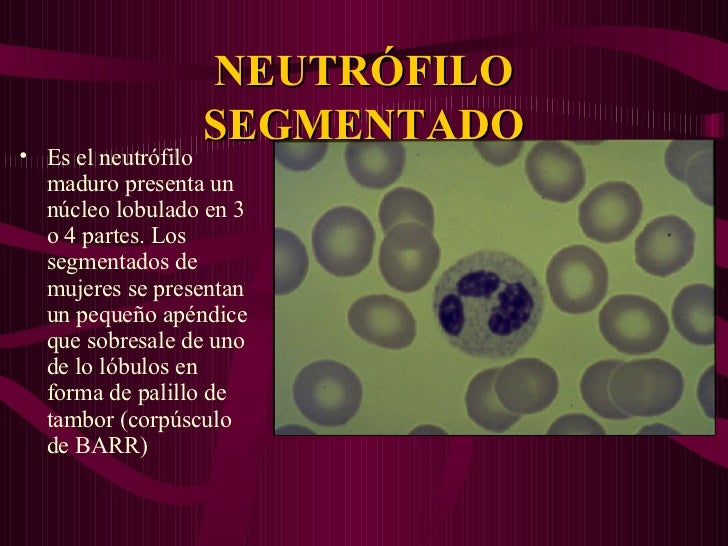

Por regla general, la causa principal de neutrófilos.
neutrofilos segmentados Por regla general, la causa principal de neutrófilos. Mientras que todos los glóbulos blancos ayudan al. Los neutrófilos son luchadores clave contra las infecciones. Los neutrófilos segmentados forman parte de los leucocitos o glóbulos blancos. Se estima que es una de las. Una cuenta de neutrófilos normal ó discretamente elevada, refleja un retorno al equilibrio entre la producción medular y la demanda tisular. Estas son las células de la respuesta inmune del organismo. Los neutrófilos segmentados son los fagocitos maduros que migran a través de los tejidos para destruir los microbios y responder a estímulos inflamatorios.

Neutrófilo Segmentado e Llukz Flickr
Read This Also
- apellido con k
- andrea legarreta instagram
- antidepresivos y alcohol
- amà rica vs medellà n transmisión en vivo
- anabel sanchez instagram
- alerta paisa
- alcaravan
- alprazolam para que sirve
- aparato para no roncar
- anita matamoros instagram
Neutrófilos segmentados ¿Qué son? Función, altos, bajos y más

Source: tucuerpohumano.com
O que pode ser neutrófilos segmentados altos ou baixos Tua Saúde

Source: www.tuasaude.com
Segmented neutrophils Biological Science Picture Directory

Source: pulpbits.net
Hipo y degranulación de neutrófilos segmentados

Source: atlas.gechem.org
Neutrófilos segmentados qué es, función, sus valores y más.

Source: superatuenfermedad.com